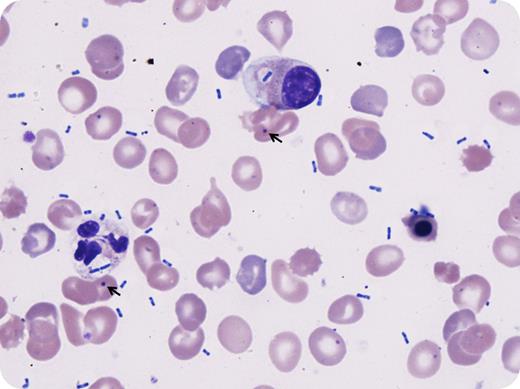
A 24-year-old man presented to the emergency room with respiratory distress and altered mental status. He had a past medical history of pyruvate kinase deficiency with status postsplenectomy at 6 years of age. On examination, he was hypotensive and febrile; he was intubated on admission. Workup showed macrocytic anemia, leukocytosis, and slight neutrophilia, with elevated lactate, prothrombin time, and activated partial thromboplastin time, mixed respiratory and metabolic acidosis, and hypoxemia. Chest radiograph demonstrated dense bilateral pulmonary infiltrates. Peripheral blood smear showed leukoerythroblastosis with left-shifted granulocytes exhibiting toxic morphology and numerous extracellular and intracellular bacilli (Wright stain; original magnification ×100). Additional findings compatible with asplenic status were also noted, including numerous nucleated red blood cells, Pappenheimer bodies, and Howell-Jolly bodies (arrows). Despite broad-spectrum antibiotics, supportive care, and multiple vasopressors, he remained in intractable septic shock and unfortunately died. Blood cultures grew Klebsiella pneumoniae that was pan-sensitive. / Asplenic patients lack splenic macrophages necessary for eliminating opsonized encapsulated organisms. Prophylactic vaccination, particularly with pneumococcal vaccine (which the patient had received), is important to prevent some life-threatening infections in asplenic patients. However, vaccination is currently unavailable for K pneumoniae and it remains one of the common causes of these rare, overwhelming, and rapidly life-threatening infections in patients who are splenectomized for congenital hemolytic anemias.

A 24-year-old man presented to the emergency room with respiratory distress and altered mental status. He had a past medical history of pyruvate kinase deficiency with status postsplenectomy at 6 years of age. On examination, he was hypotensive and febrile; he was intubated on admission. Workup showed macrocytic anemia, leukocytosis, and slight neutrophilia, with elevated lactate, prothrombin time, and activated partial thromboplastin time, mixed respiratory and metabolic acidosis, and hypoxemia. Chest radiograph demonstrated dense bilateral pulmonary infiltrates. Peripheral blood smear showed leukoerythroblastosis with left-shifted granulocytes exhibiting toxic morphology and numerous extracellular and intracellular bacilli (Wright stain; original magnification ×100). Additional findings compatible with asplenic status were also noted, including numerous nucleated red blood cells, Pappenheimer bodies, and Howell-Jolly bodies (arrows). Despite broad-spectrum antibiotics, supportive care, and multiple vasopressors, he remained in intractable septic shock and unfortunately died. Blood cultures grew Klebsiella pneumoniae that was pan-sensitive.
Asplenic patients lack splenic macrophages necessary for eliminating opsonized encapsulated organisms. Prophylactic vaccination, particularly with pneumococcal vaccine (which the patient had received), is important to prevent some life-threatening infections in asplenic patients. However, vaccination is currently unavailable for K pneumoniae and it remains one of the common causes of these rare, overwhelming, and rapidly life-threatening infections in patients who are splenectomized for congenital hemolytic anemias.
A 24-year-old man presented to the emergency room with respiratory distress and altered mental status. He had a past medical history of pyruvate kinase deficiency with status postsplenectomy at 6 years of age. On examination, he was hypotensive and febrile; he was intubated on admission. Workup showed macrocytic anemia, leukocytosis, and slight neutrophilia, with elevated lactate, prothrombin time, and activated partial thromboplastin time, mixed respiratory and metabolic acidosis, and hypoxemia. Chest radiograph demonstrated dense bilateral pulmonary infiltrates. Peripheral blood smear showed leukoerythroblastosis with left-shifted granulocytes exhibiting toxic morphology and numerous extracellular and intracellular bacilli (Wright stain; original magnification ×100). Additional findings compatible with asplenic status were also noted, including numerous nucleated red blood cells, Pappenheimer bodies, and Howell-Jolly bodies (arrows). Despite broad-spectrum antibiotics, supportive care, and multiple vasopressors, he remained in intractable septic shock and unfortunately died. Blood cultures grew Klebsiella pneumoniae that was pan-sensitive.
Asplenic patients lack splenic macrophages necessary for eliminating opsonized encapsulated organisms. Prophylactic vaccination, particularly with pneumococcal vaccine (which the patient had received), is important to prevent some life-threatening infections in asplenic patients. However, vaccination is currently unavailable for K pneumoniae and it remains one of the common causes of these rare, overwhelming, and rapidly life-threatening infections in patients who are splenectomized for congenital hemolytic anemias.
For additional images, visit the ASH IMAGE BANK, a reference and teaching tool that is continually updated with new atlas and case study images. For more information visit http://imagebank.hematology.org.
This feature is available to Subscribers Only
Sign In or Create an Account Close Modal